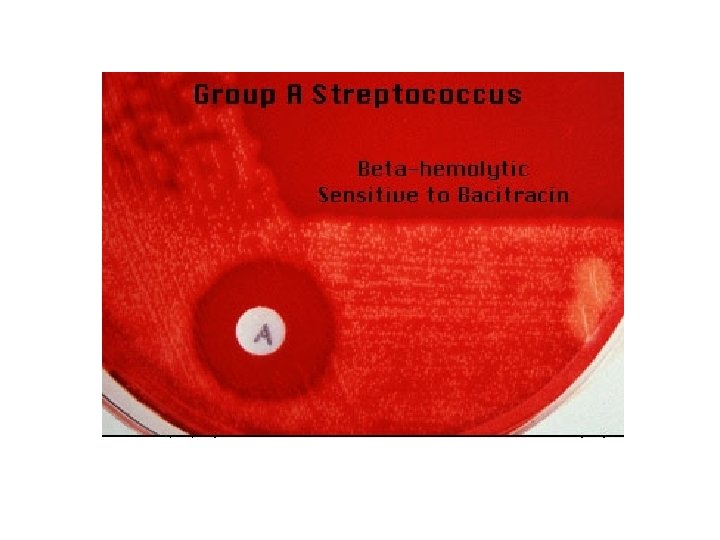
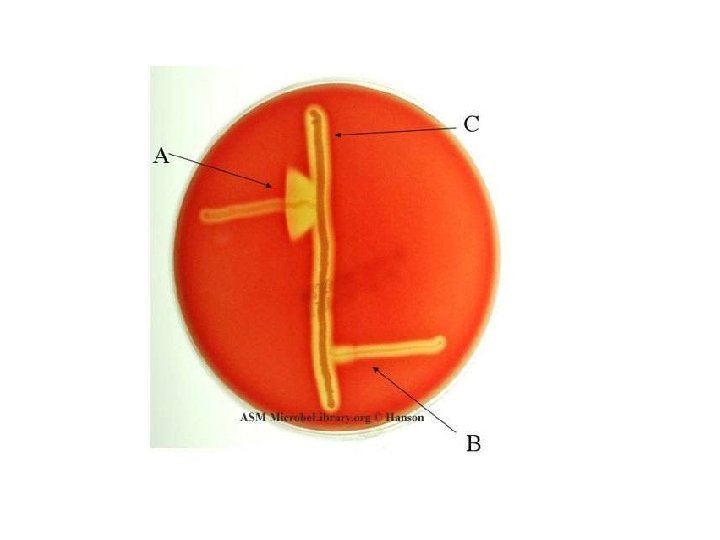

Streptococcusgram positive coccus Dr Hala Al Daghistani Streptococci

- Slides: 23
Streptococcus(gram positive coccus) Dr. Hala Al Daghistani
Streptococci Facultative anaerobe Gram-positive usually chains (sometimes pairs) Catalase negative Non motile Hemolysins Lancefield Groups (C-carbohydrate in cell wall) 18 antigens 2
THE STREPTOCOCCI ARE GRAM-POSITIVE SPHERICAL BACTERIA THAT CHARACTERISTICALLY FORM PAIRS OR CHAINS DURING GROWTH. SOME ARE MEMBERS OF THE NORMAL HUMAN MICROBIOTA; OTHERS ARE ASSOCIATED WITH IMPORTANT HUMAN DISEASES. NO ONE SYSTEM SUFFICES TO CLASSIFY THEM. CLASSIFICATION A. HEMOLYSIS MANY STREPTOCOCCI ARE ABLE TO HEMOLYSED RBCS IN VITRO IN VARYING DEGREES. COMPLETE DISRUPTION OF ERYTHROCYTES WITH CLEARING OF THE BLOOD AROUND THE BACTERIAL GROWTH IS CALLED Β HEMOLYSIS. INCOMPLETE LYSIS OF ERYTHROCYTES WITH REDUCTION OF HEMOGLOBIN AND THE FORMATION OF GREEN PIGMENT IS CALLED Α - HEMOLYSIS. OTHER STREPTOCOCCI ARE NONHEMOLYTIC (SOMETIMES CALLED Γ- HEMOLYSIS).
hemolysis reaction - sheep blood agar • α (alpha) – partial hemolysis – green color – S. pneumoniae and viridans • β (beta) – complete clearing • γ (gamma) - no lysis 4
B. GROUP-SPECIFIC SUBSTANCE (LANCEFIELD CLASSIFICATION) THIS CARBOHYDRATE IS CONTAINED IN THE CELL WALL OF MANY STREPTOCOCCI AND FORMS THE BASIS OF SEROLOGIC GROUPING INTO LANCEFIELD GROUPS A – H AND K – U. C. CAPSULAR POLYSACCHARIDES THE ANTIGENIC SPECIFICITY OF THE CAPSULAR POLYSACCHARIDES IS USED TO CLASSIFY STREPTOCOCCUS PNEUMONIAE INTO MORE THAN 90 TYPES.
Strep Virulence Factors
Ø M- PROTEIN - major target (hair like projection) - strain variation (antigenicity) - re-infection occurs with different strain (150, types of M protein, a person can have repeated infections with S pyogenes of different M types). • lipoteichoic acid ( attachment of streptococci to epithelial cells). Capsule ( Anti-phagocytic) (mucoid strains) 8
9
Virulence factors of S. pyogenes • Streptolysin( O & S), Antistreptolysin O (ASO). ASO serum titer in excess of 160– 200 units is considered abnormally. (S = O 2 stable; O = O 2 labile) – Streptokinase (Break down clots) – DNase (depolymerize) – Hyaluronidase – Proteases – C 5 a peptidase (Decrease chemotaxis) • Toxins Exotoxins – Pyrogenic toxin or erythrogenic toxin(A, B, C), responsible for Streptococcal toxic shock syndrome and scarlet fever, superantigens – Increase immune cytokines – Promote fever • TSS like syndrome (Sepsis)
A. DISEASES ATTRIBUTABLE TO INVASION BY S PYOGENES, ΒHEMOLYTIC GROUP A STREPTOCOCCI PUERPERAL FEVER, CELLULITIS, ERYSIPELAS, BACTEREMIA OR SEPSIS NECROTIZING FASCIITIS (STREPTOCOCCAL GANGRENE, FLESH EATING BACTERIA). B. DISEASES ATTRIBUTABLE TO LOCAL INFECTION WITH S PYOGENES AND THEIR BYPRODUCTS STREPTOCOCCAL SORE THROAT, STREPTOCOCCAL INFECTION OF SUPERFICIAL LAYERS OF SKIN( IMPETIGO), C. INVASIVE GROUP A STREPTOCOCCAL INFECTIONS, STREPTOCOCCAL TOXIC SHOCK SYNDROME, AND SCARLET FEVER D. POSTSTREPTOCOCCAL DISEASES (RHEUMATIC FEVER, GLOMERULONEPHRITIS- SPEB)
GAS: Strep pyogenes
STREPTOCOCCUS AGALACTIAE (GBS) GROUP B STREPTOCOCCI ARE PART OF THE NORMAL VAGINAL FLORA AND LOWER GASTROINTESTINAL TRACT IN 5– 30% OF WOMEN. INFECTION DURING THE FIRST MONTH OF LIFE MAY PRESENT AS FULMINANT SEPSIS, MENINGITIS, OR RESPIRATORY DISTRESS SYNDROME. IMPORTANT PATHOGENS AMONG PREGNANT WOMEN AND THEIR NEONATES.
VIRIDANS STREPTOCOCCUS THE VIRIDANS STREPTOCOCCI ARE THE MOST PREVALENT MEMBERS OF THE NORMAL MICROBIOTA OF THE URT. - PRINCIPAL CAUSE OF ENDOCARDITIS ON NORMAL AND ABNORMAL HEART VALVES.
Viridans Streptococcus • Alpha hemolysis • No Lancefield groups • Diseases – Dental Caries – Endocarditis – Examples • Strep mitis • Strep mutans • Strep oralis • Strep sanguis • Strep salivarius
STREPTOCOCCUS PNEUMONIA THE PNEUMOCOCCI (S PNEUMONIAE) ARE GRAM-POSITIVE DIPLOCOCCI - LANCET SHAPED OR ARRANGED IN CHAINS - POSSESSING A CAPSULE OF POLYSACCHARIDE (91 TYPE) - PNEUMOCOCCI ARE NORMAL INHABITANTS OF THE URT OF 5– 40% OF HUMANS AND CAN CAUSE PNEUMONIA, SINUSITIS, OTITIS, BRONCHITIS, BACTEREMIA, MENINGITIS, AND OTHER INFECTIONS.
Strep. pneumoniae
Quellung Reaction When pneumococci of a certain type are mixed with specific antipolysaccharide serum of the same type—or with polyvalent antiserum (OMNISERUM)—on a microscope slide